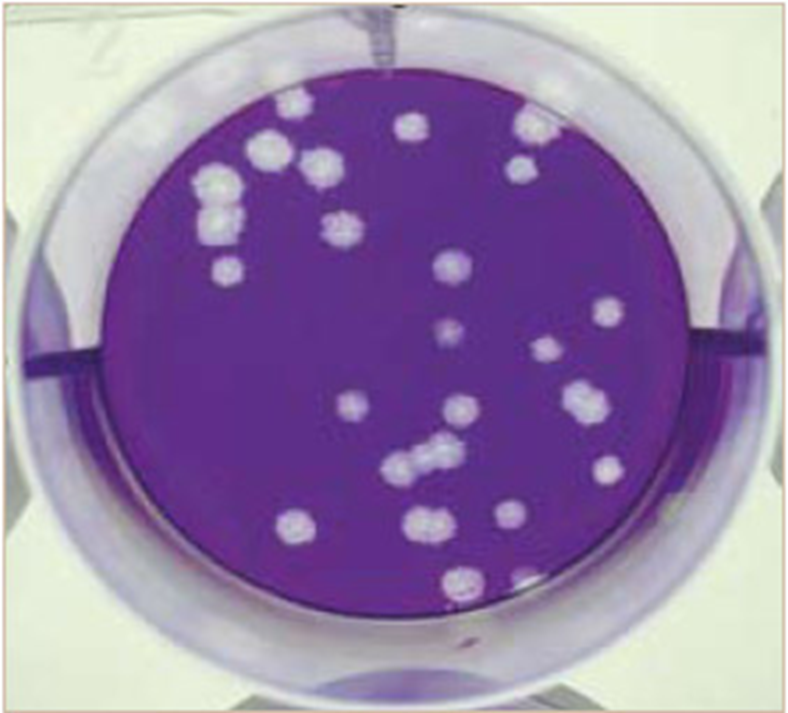
<p>A <strong>plaque assay</strong> measures the number of <strong>infectious virus particles</strong> in a sample.</p><p>A virus solution is added to a <strong>monolayer of host cells</strong>, where infection and <strong>cell lysis</strong> create <strong>clear zones called plaques</strong>.</p><ul><li><p>each plaque represents one virion</p></li></ul><p></p>

ch 13a, 13b unit 3 micro
1/77
There's no tags or description
Looks like no tags are added yet.
Name | Mastery | Learn | Test | Matching | Spaced | Call with Kai |
|---|
No analytics yet
Send a link to your students to track their progress
78 Terms
capsid
protective protein coat
nucleic acid of virus
either RNA or DNA
nucleocapsid
the capsid and nucleic acid contents
tail
long helical protein component used for attachment to host cells
spike proteins
project from capsid in tailless viruses
needed for attachment to host cells
envelope
lipid bilayer derived from the host cell that surrounds the capsid.
Found only in animal viruses.
Viruses without an envelope are called “naked”
naked virus
no envelope
viral attachment
can only enter host cells that express specific proteins on their surface
like a key to a lock
virus attaches to receptor protein and insert its genetic information into host cell
phage attachment
phage attaches to specif protein receptors of host
genome entry (phage)
tail contracts and phage DNA is injected into bacterial cell
phage coat left outside
synthesis (phage)
phage genome is transcribed phage proteins synthesized
DNA is replicated, other virion components made
host DNA degraded
assembly (phage, step 4)
phage components assembled into mature virions
release
bacterial cell lyses and new infectious virions are released
step 5
lytic (phage)
viruses that lyse the host cell every time they are released
also called virulent phages
filamentous (phage)
viruses that leak out of extrude without killing host cells

temperate (phage)
viruses that integrate their DNA into the genome of the bacteria they infect
or DNA replicates as a plasmid
90% of all viruses are __ phages
prophage
a bacteriophage (virus) genome that has integrated into a bacterium's chromosome or exists as an plasmid, residing in a dormant, non-infectious state known as lysogeny

lysogenic state
virus is incorporated into the host DNA

lysogenic conversion
a process where a bacterium acquires new, inheritable genetic traits—often increased virulence—by integrating DNA from a temperate bacteriophage into its own genome
transduction
bacterial viruses (bacteriophages) mistakenly carry bacterial genes from one host to the next

Generalized transduction
any genes of the donor cell can be transferred.
An error occurs during construction of the virus and a fragment of bacterial DNA is packaged in the protein coat of the virus.

Specialized transduction
only a few specific genes can be transferred.
This is carried out by only temperate phages

Generalized transduction temperate phages
performed by virulent and temperate phages
recipient host cell is not lysed because the genetic information within the new phage is incomplete.
specialized transduction temperate phages
only bacterial genes located near the prophage on the chromosome may be transferred to the next host cell.
limited to a single bacterial species and often to only a few strains of that species
what is the host range of phages?
mainly in cell wall but sometimes
pili
flagella
where are the receptors located for phage attachment
Naked viruses
no envelope, just nucleocapsid.
Spike proteins are on the capsid
Enveloped virus
nucleocapsid surrounded by lipid membrane.
Spike proteins are on the envelope
only on animal viruses
envelope
what do phages lack compared to animal viruses?
segmented viruses
RNA viruses with genomes divided into multiple, distinct linear molecules, rather than a single molecule
ex influenza has 8 RNA molecules
attachment (animal virus)
virus attaches to specific receptor proteins on the host cell surface
entry (animal virus)
Naked viruses enter the host cell through endocytosis
Enveloped viruses enter through fusion of the envelope with the host cell plasma membrane
Both capsids enter host cell

Uncoating (animal virus)
The nucleic acids are released from the capsid
step 3

Replication (animal virus)
RNA/DNA is replicated. Proteins are produced in the form of polyproteins
which must be cleaved by viruses-encoded protease to function.
Inhibited by protease inhibitor drugs
step 4

Assembly (animal virus)
insertion of nucleic acid into protein coat
step 5

Release (animal virus)
step 5
Naked viruses are released from the cell by lysis.
Enveloped viruses are released through the process of budding.

Retroviruses
single-stranded enveloped RNA viruses.
Most prominent of this class of virus is HIV
Reverse transcriptase
an enzyme that is contained in the capsid of retroviruses and is responsible for converting the RNA genome into DNA.
RNA→ DNA
Retroviruse RNA
RNA genome of a retrovirus must first be converted to a DNA copy for the virus to be replicated
DNA copy is then integrated into the host genome
From here, viral genes are expressed and the virus is reproduced
RNA→DNA→DNA in host genome→Virus replicated
Acute Infections
relatively short duration (generally less than 2 weeks).
Virus disappears after disease ends, and is no longer detectable in any tissue of the host organism’s body
ex influenza, mumps, polio

Persistent Infections
the viruses or their genomes are continually present in the body and virions are released from infected cells. 3 categories
virus is continually replicating
Latent Infection
Chronic Infection
Slow Infection

latent infection
a type of infection where a pathogen (usually a virus or bacteria) resides in the body in a dormant, inactive state without causing symptoms or active disease
infection is beat by host immune system but reactivated later due to hiding in nerve cells
ex Herpes Simplex 1 and 2, Varicella-Zoster, Epstein-Barr

Chronic Infections
long-term, persistent illnesses where the immune system fails to eliminate the virus
virus demonstrated at all times
Disease symptoms may be present or absent during an extended period of time, or may develop late
ex Hepatitis B, Hepatitis C

Slow Infections
Following initial infection, the infectious agent gradually increases in amount over a very long time (years) during which no significant symptoms are apparent
eventually a slowly progressive lethal disease ensues
ex HIV
latent

mechanism is integration of a DNA virus into the host chromosome followed by expression of oncogenes
Oncogenes are often altered forms of normal cell’s genes coding for proteins involved in regulating cell growth
results in uncontrolled growth of host cells
what is the most common mechanism where viruses cause 20% of all human tumors?
Hepatitis B/C- hepatic carcinoma
Human Papillomaviruses- cervical, penile, anal cancers
Human Herpes Virus 8- Kaposi’s sarcoma (cancer of skin and internal organs, common in AIDS patients
what viruses are associated with tumor development?
uses hemagglutinin
What does influenza do to attach to host cells?
Antigenic drift is the accumulation of minor mutations in the hemagglutinin protein of the influenza virus. These small changes alter the virus enough that the immune system does not recognize it from previous infections, allowing the flu to infect people again in later seasons
What is antigenic drift and why does it allow the flu to infect people in consecutive years?
Antigenic shift occurs when genetic reassortment between two viruses infecting the same cell results in a new virus with different hemagglutinin genes, allowing it to evade existing human antibodies.
What is antigenic shift in influenza viruses?
Antigenic shift creates major changes in influenza surface antigens through gene segment reassortment, producing a virus that human populations have little or no immunity to, leading to pandemics every ~10–30 years.
Why can antigenic shift lead to influenza pandemics?
Feature | Antigenic Drift | Antigenic Shift |
|---|---|---|
Type of change | Minor mutations | Major genetic change |
Mechanism | Point mutations in hemagglutinin genes | Genetic reassortment between different viruses |
Frequency | Happens continually | Occurs every 10–30 years |
Result | Seasonal flu infections | Pandemics |
Immunity | Partial immune recognition | Little to no population immunity |
What is the difference between antigenic drift and antigenic shift in influenza viruses?
Hemagglutinin (HA) is a surface glycoprotein on the influenza virus that binds to receptors on host cells, allowing the virus to attach and enter the cell.
What is hemagglutinin (HA) in the influenza virus?
Viruses must be cultivated in host cells because they can not multiply themselves
what is the method on how to study viruses?
Primary tissue culture (viral growth method
tissue cultures prepared directly from the tissues of an animal.
Cells die after 50-100 division, so new primary cultures must be continually started
Cell lines (viral growth method
tissue cultures prepared from tumor cells. Tumor cells multiply indefinitely.
However, conclusions about “normal cells” can not be made
Embryonated chicken eggs (viral growth method)
used to grow influenza
Living animals (viral growth method)
necessary for some virus strains
A plaque assay measures the number of infectious virus particles in a sample.
A virus solution is added to a monolayer of host cells, where infection and cell lysis create clear zones called plaques.
each plaque represents one virion
what is Plaque Assay and what does it quantify

Hemagglutination occurs when some viruses bind to and clump red blood cells (RBCs) by attaching to receptors on multiple cells.
Caused by viral surface proteins (e.g., hemagglutinin in influenza)
Measured using serial dilutions of a virus mixed with RBCs
Virus titer = highest dilution that still shows agglutination
What is hemagglutination and how is it used to measure virus concentration?
Attachment
Entry
Replication (DNA/RNA created)
Assembly
Release (naked lyse, enveloped bud)
what are the steps of animal virus replication?
viroid
small, circular, single-stranded RNA molecules that lack a protein coat
infect only plants!
Prions
infectious particles that contain ONLY protein (no nucleic acids)
Infectious prions
similar structure to normal prions, but mutation has caused the protein to have a different folding pattern.
mutant prion is resistant to protease
Normal prion
proteins found in brains of all vertebrates.
replicates by converting the normal host protein into mutant prions by altering its folding pattern.
how do prions multiply?
spongiform encephalopathies (holes in brain)
what do prions do to tissue?
when prions aggregate in insoluble masses (plaques) outside the nerve cells. Nerve cell death results.
prion disease is caused by
Scrapie
Mad Cow Disease
Chronic Wasting Disease
Creutzfeldt-Jakob Disease
Kuru
Cause
behavioral changes, anxiety, insomnia, fatigue, muscle jerks, lack of coordination, dementia, and death
what are the 5 prion diseases?

Attachment (cell wall)
Genome entry
synethesis
assembly
release
what are the steps in phage replication?
virulent(lytic) and temperate phages
generalized transduction is preformed by
Hep B
Chronic,
Affects- Hepatocytes
causes- hepatitis, cirrhosis, hepatocarcinoma

Hep C
Chronic,
Affect- Hepatocytes
causes- hepatitis, cirrhosis, hepatocarcinoma

Herpes simplex type I
Latent
affects neurons of sensory ganglia
causes- oral herpes

Herpes simplex type 2
latent
affects- neurons of sensory ganglia
causes- genital herpes

varicella zoster (chickenpox)
Latent
affects- sensory ganglia cells
causes- chickenpox and shingles

cytomegalovirus
Latent
affects- salvary glands, kidneys, and leakocytes
Causes- pneumonia, eye infection

epstein-Barr virus
latent
causes- B lymphocytes
disease- mononucleosis

Human immunodeficiency virus (HIV)
Chronic/slow
Affects- T lymphocytes
causes- AIDS
